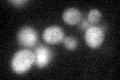
YOR113W
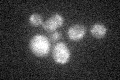
YOR113W

View description
Zinc-finger transcription factor, involved in induction of CLN3 transcription in response to glucose; genetic and physical interactions indicate a possible role in mitochondrial transcription or genome maintenance
Localization:
Intensity:
Fold change:
Significance:
-
C’ GFP library in SD

below threshold16.62 -
N' NOP1pr-GFP in SD

nucleus45.9271 -
N' TEF2pr-mCherry in SD

nucleus31.1964 -
N' NATIVEpr-GFP in SD

nucleus20.2236 -
N' TEF2pr-VC and Cyto-VN in SD

nucleus30.9755 -
C’ GFP library in SD+DTT
cytosol16.931.01No -
C’ GFP library in SD+H2O2
cytosol17.451.04No -
C’ GFP library in Starvation Media

cytosol15.150.91No -
C’ GFP library on the background of Pup2-DaMP

below threshold -
C’ GFP library on the background of CCT mutant

below threshold17.48431.05112No
